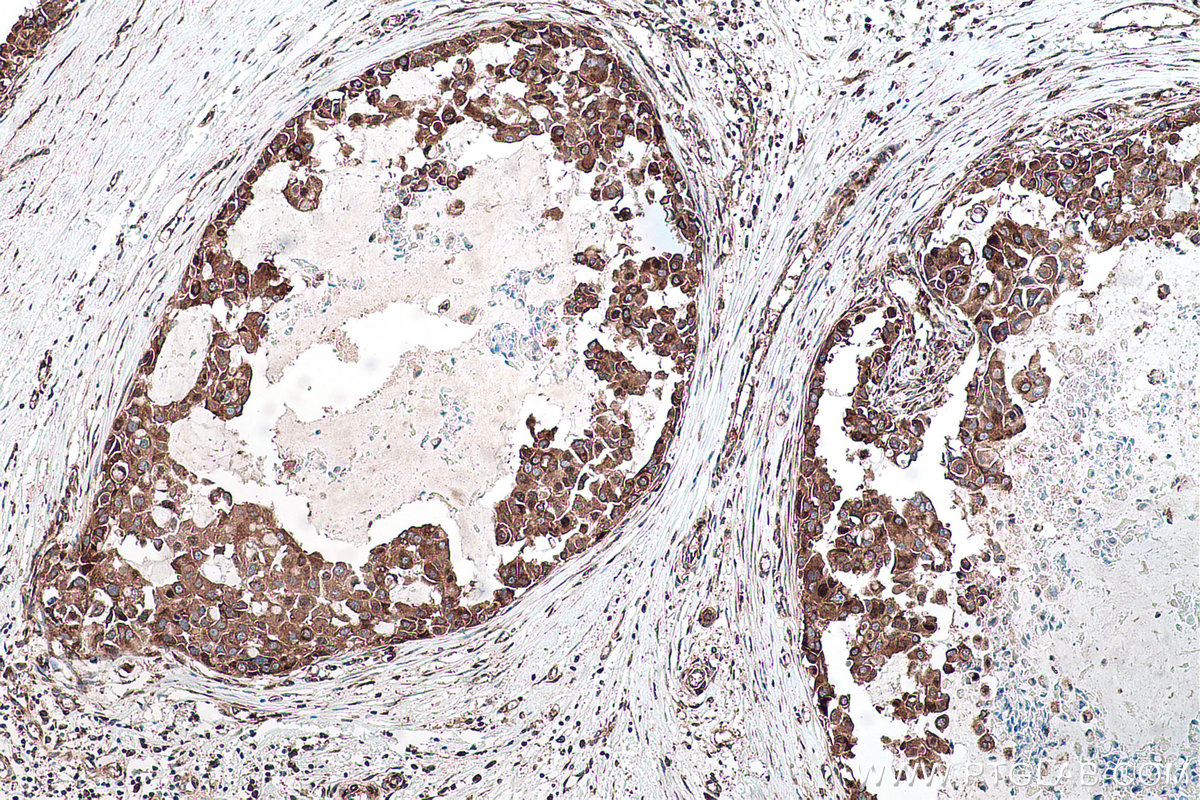
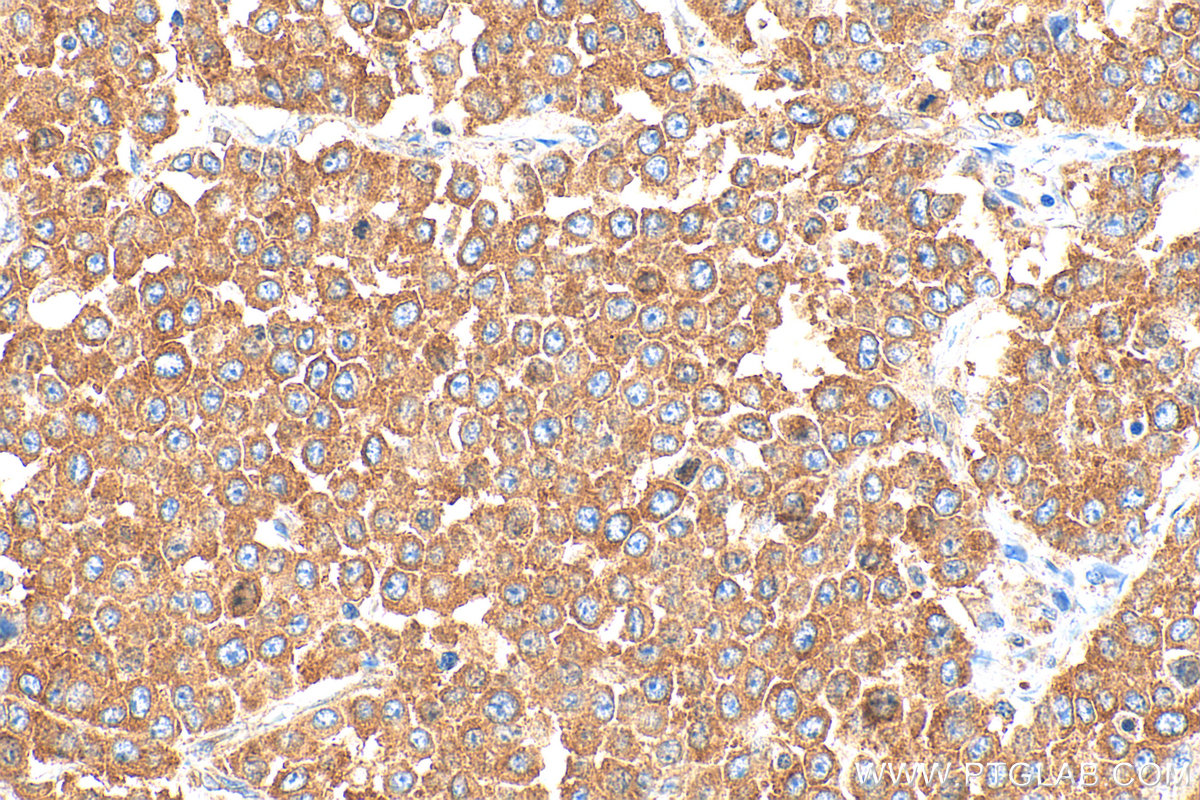

验证数据展示
经过测试的应用
| Positive WB detected in | HEK-293 cells, HeLa cells, Jurkat cells, MCF-7 cells, MDA-MB-231 cells, NIH/3T3 cells |
| Positive IHC detected in | human renal cell carcinoma tissue, human breast cancer tissue, human colon cancer tissue, human placenta tissue, human prostate cancer tissue, human tonsillitis tissue, mouse colon tissue, rat colon tissue Note: suggested antigen retrieval with TE buffer pH 9.0; (*) Alternatively, antigen retrieval may be performed with citrate buffer pH 6.0 |
| Positive IF/ICC detected in | HeLa cells |
推荐稀释比
| 应用 | 推荐稀释比 |
|---|---|
| Western Blot (WB) | WB : 1:5000-1:50000 |
| Immunohistochemistry (IHC) | IHC : 1:500-1:2000 |
| Immunofluorescence (IF)/ICC | IF/ICC : 1:200-1:800 |
| It is recommended that this reagent should be titrated in each testing system to obtain optimal results. | |
| Sample-dependent, Check data in validation data gallery. | |
产品信息
20339-1-AP targets YBX1 in WB, IHC, IF/ICC, IP, CoIP, ChIP, RIP, ELISA applications and shows reactivity with human, mouse, rat samples.
| 经测试应用 | WB, IHC, IF/ICC, ELISA Application Description |
| 文献引用应用 | WB, IHC, IF, IP, CoIP, ChIP, RIP |
| 经测试反应性 | human, mouse, rat |
| 文献引用反应性 | human, mouse, rat, pig |
| 免疫原 |
CatNo: Ag14129 Product name: Recombinant human YBX1 protein Source: e coli.-derived, PGEX-4T Tag: GST Domain: 134-303 aa of BC010430 Sequence: QGSKYAADRNHYRRYPRRRGPPRNYQQNYQNSESGEKNEGSESAPEGQAQQRRPYRRRRFPPYYMRRPYGRRPQYSNPPVQGEVMEGADNQGAGEQGRPVRQNMYRGYRPRFRRGPPRQRQPREDGNEEDKENQGDETQGQQPPQRRYRRNFNYRRRRPENPKPQDGKET 种属同源性预测 |
| 宿主/亚型 | Rabbit / IgG |
| 抗体类别 | Polyclonal |
| 产品类型 | Antibody |
| 全称 | Y box binding protein 1 |
| 别名 | CBF A, CBF-A, CCAAT-binding transcription factor I subunit A, DBPB, DNA-binding protein B |
| 计算分子量 | 324 aa, 36 kDa |
| 观测分子量 | 36-56 kDa |
| GenBank蛋白编号 | BC010430 |
| 基因名称 | YBX1 |
| Gene ID (NCBI) | 4904 |
| RRID | AB_10665424 |
| 偶联类型 | Unconjugated |
| 形式 | Liquid |
| 纯化方式 | Antigen affinity purification |
| UNIPROT ID | P67809 |
| 储存缓冲液 | PBS with 0.02% sodium azide and 50% glycerol, pH 7.3. |
| 储存条件 | Store at -20°C. Stable for one year after shipment. Aliquoting is unnecessary for -20oC storage. |
背景介绍
Y box binding protein 1(YBX1) is one of cis-acting elements which has a role in regulation of the expression of HLA class II genes. YBX1 is great of importance in regulation of PTP1B expression. It can bind to splice sites mediate pre-mRNA alternative splicing regulation. Also, it involves the regulation of translation by modulation of the interaction between the mRNA and eukaryotic initiation factors. Its transcriptional activity on the multidrug resistance gene MDR1 is enhanced in presence of the APEX1 acetylated form at 'Lys-6' and 'Lys-7'. The secreted form acts as an extracellular mitogen and stimulates cell migration and proliferation. The calculated molecular weight of YBX1 is 36 kDa, but modified YBX1 is about 36-56 kDa (PMID: 27384875 ). Recently, researchers developed a biomimetic nanoplatform to deliver RNA piR-RCC specifically into RCC tumors. This RNA interacts with YBX1 to inhibit tumor proliferation and metastasis (PMID: 40411401).
实验方案
| Product Specific Protocols | |
|---|---|
| IF protocol for YBX1 antibody 20339-1-AP | Download protocol |
| IHC protocol for YBX1 antibody 20339-1-AP | Download protocol |
| WB protocol for YBX1 antibody 20339-1-AP | Download protocol |
| Standard Protocols | |
|---|---|
| Click here to view our Standard Protocols |
发表文章
| Species | Application | Title |
|---|---|---|
Adv Sci (Weinh) ALKBH5-Mediated M6A Demethylation of G3BP1 Attenuates Ferroptosis Via Cytoplasmic Retention of YBX1/p53 in Diabetic Myocardial Ischemia-Reperfusion Injury | ||
Sci Adv Profiling and functional characterization of maternal mRNA translation during mouse maternal-to-zygotic transition. | ||
Nat Commun Targeting USP47 overcomes tyrosine kinase inhibitor resistance and eradicates leukemia stem/progenitor cells in chronic myelogenous leukemia.
| ||
Cell Death Differ YB-1 is a positive regulator of KLF5 transcription factor in basal-like breast cancer.
| ||
Cell Rep Coordinated post-transcriptional control of oncogene-induced senescence by UNR/CSDE1.
|